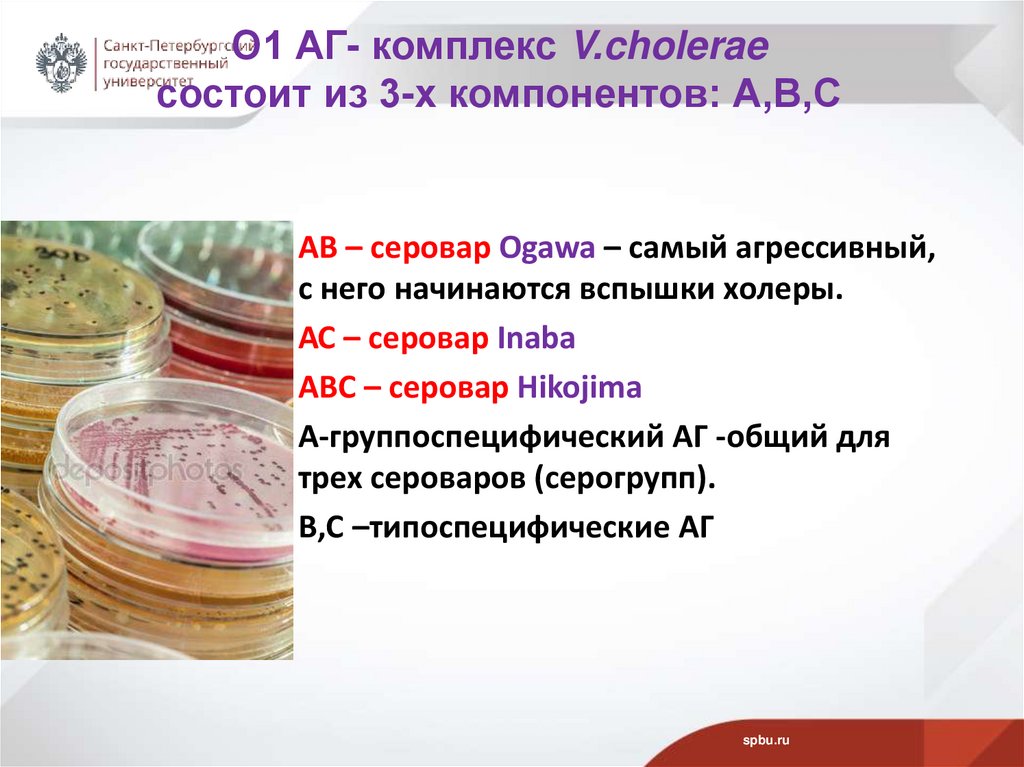
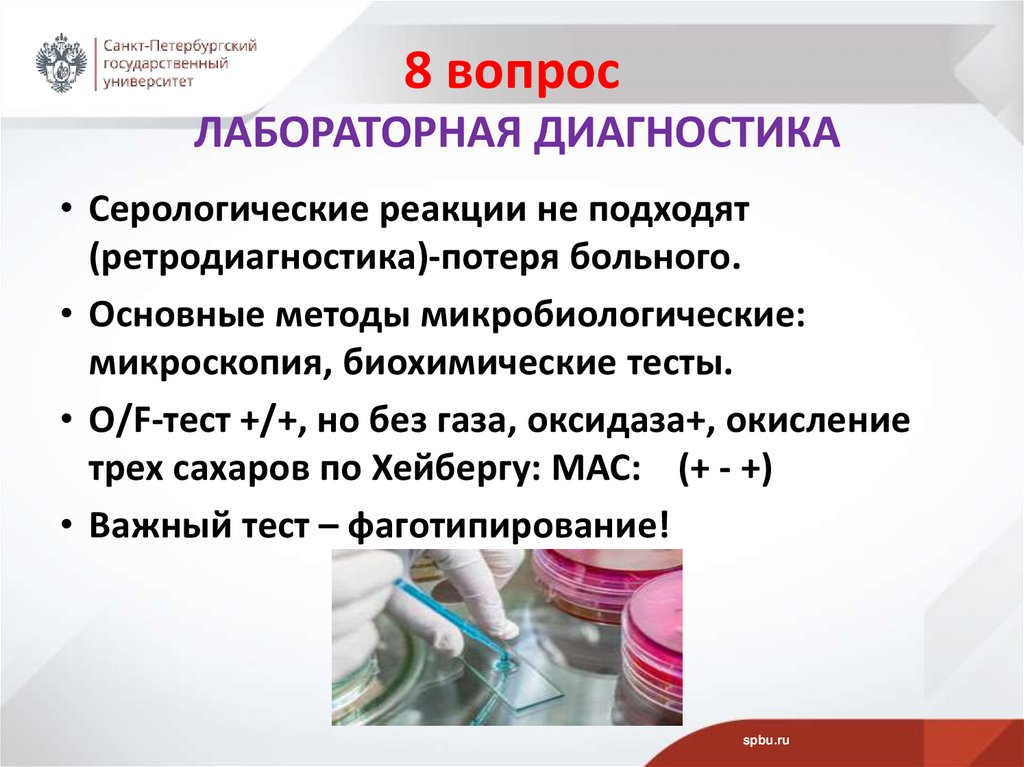
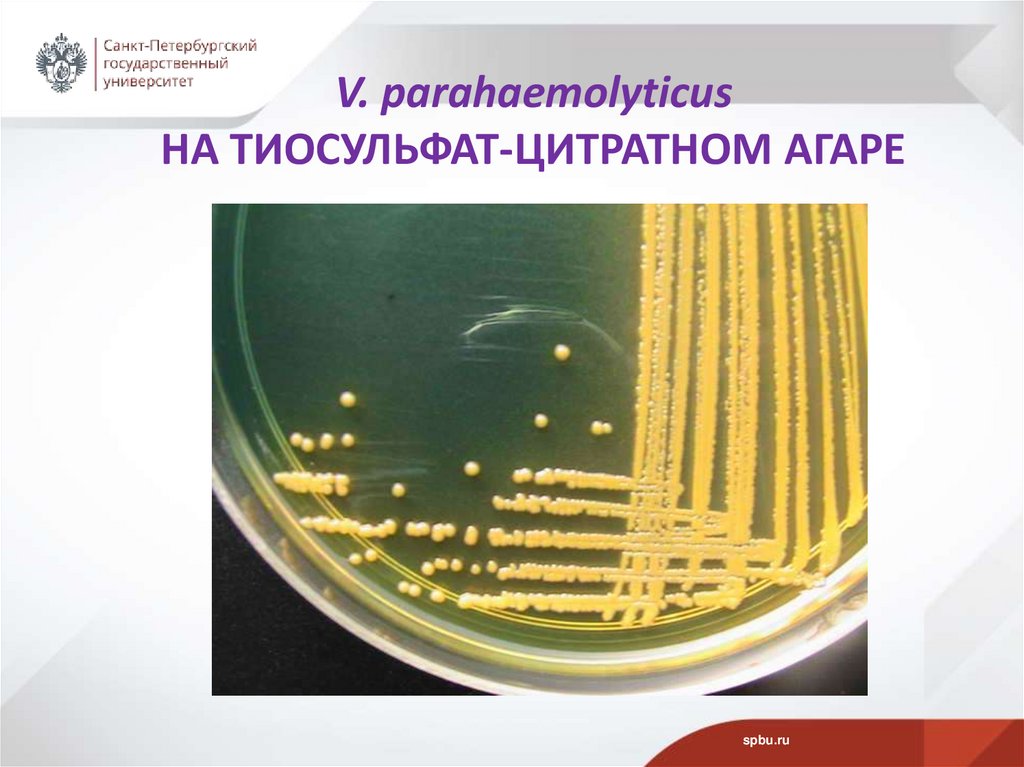
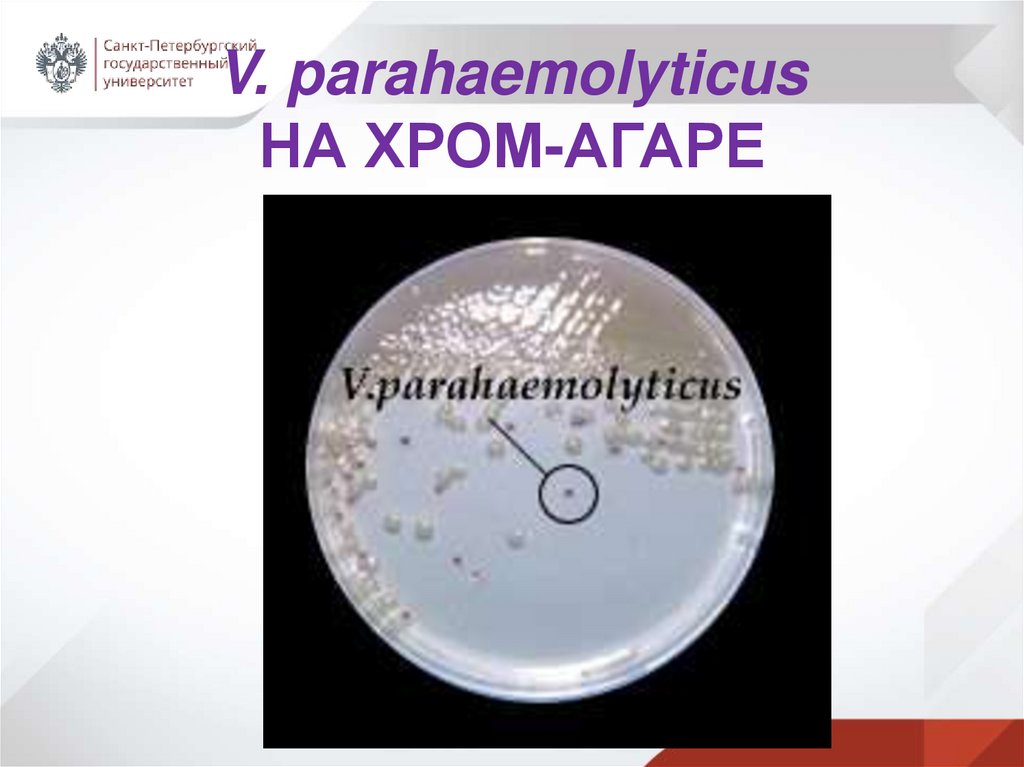

Similar presentations:
Патогенные вибрионы сем. Vibrionaceae
1. Патогенные вибрионы сем. Vibrionaceae
ПАТОГЕННЫЕ ВИБРИОНЫСЕМ. VIBRIONACEAE
СПбГУ
22.02.2024
д.б.н., проф.
Рыбальченко О.В.
2. ПЛАН
1.2.
3.
4.
5.
6.
7.
8.
9.
10.
Vibrio cholerae–возбудитель холеры. Актуальность
проблемы.
Сапронозные инфекции
Характеристика сем. Vibrionaceae
Род Vibrio
Биотипы холерного вибриона
АГ- свойства вибрионов. Строение О1-АГ комплекса
Главный фактор патогенности - экзотоксин - холероген,
факторы патогенности Vibrio cholerae
Особенности лабораторной диагностики холеры
Фаготипирование Vibrio cholerae
Характеристика возбудителей вибриозов
spbu.ru
3. 1 вопрос Vibrio cholerae–ВОЗБУДИТЕЛЬ ХОЛЕРЫ Холера – острая антропонозная высококонтагиозная кишечная инфекция,
характеризующаяся разнообразиемклинических проявлений от тяжелых форм
до легкой диареи, включая
вибрионосительство.
spbu.ru
4. ПРОЯВЛЕНИЯ ХОЛЕРЫ
1.Диарейный синдром.2. Нарушение водно-электролитного
баланса.
3. Обезвоживание.
Пути передачи
Фекально-оральный механизм передачи
возбудителя.
Водный, пищевой и контактно-бытовой
путь распространения.
spbu.ru
5. АКТУАЛЬНОСТЬ ПРОБЛЕМЫ
Холера – особо опасная карантинная инфекция(ООКИ).
Относится к медико-социальным проблемам.
Первые сведения о холере-античная литература.
Первая эпидемия холеры зарегистрирована в
Бенгальском заливе Индийского океана в начале
XIX в.
spbu.ru
6. ПАНДЕМИИ ХОЛЕРЫ
I пандемияначало XIX в.(1817-1823 гг.)
II пандемия
(1826-1837 гг.)
III пандемия
(1846-1862 гг.)
IV пандемия
(1864-1875 гг.)
V пандемия
(1883-1896 гг.)
VI пандемия
(1900-1925 гг.)
spbu.ru
7. Бо́лдинская осень 1830 г.
Бо́лдинская осень 1830 г.Карантин из-за холеры А.С.Пушкин провел в имении
Большое Болдино.
…Всё, всё, что гибелью грозит,
Для сердца смертного таит
Неизъяснимы наслажденья - …. «Пир во время чумы»
6 ноября 1930, Болдино
А. С. Пушкин
«…холера – премиленькая особа»
А.С.Пушкин из письма Н.Н.Гончаровой
spbu.ru
8. В НАСТОЯЩЕЕ ВРЕМЯ VII ПАНДЕМИЯ ХОЛЕРЫ (с 1961 г….) Более 150 стран, все континенты!!!
spbu.ru9. ОТЛИЧИЕ ХОЛЕРЫ ОТ ДРУГИХ ОКИ
По клиническим проявлениям отличий практически нет.Главное и единственное:
характер и объем рвотных масс и испражнений в виде
«рисового отвара».
Поэтому очень важна этиологическая диагностика!!!
spbu.ru
10. 2 вопрос ХОЛЕРА - САПРОНОЗНАЯ ИНФЕКЦИЯ (СИ)
1. Холера- холерные вибрионы Vibrio cholerae,2. легионеллез -легионеллы.
СИ вызывают свободноживущие (автономно от человека)
бактерии.
Холерные вибрионы -обитатели водной среды –
гидрофилы.
Связаны с водной экосистемой.
spbu.ru
11. ТИПЫ ИНФЕКЦИЙ
В зависимости от источника инфекции различают:1. Антропонозные инфекции – источник инфекции
человек.
2. Зоонозные инфекции – источник инфекции
животные.
3. Антропозоонозные инфекции – источник
инфекции человек и/или животные.
4. Сапронозные инфекции – источник инфекции
окружающая среда.
spbu.ru
12. ЛЕГИОНЕЛЛЫ Legionella pneumophila (Л)
Л – обитатели тёплых пресных водоёмов,факультативный внутриклеточный паразит некоторых
простейших.
Обитают в системах кондиционирования, душевых установках.
Аспирационный путь передачи инфекции.
Л вызывают легионеллёз «болезнь легионеров»- интоксикация,
лихорадка, пневмония, поражение ЖКТ, ЦНС, почек.
Инкуб. период – от неск. до 48 час. Основные симптомы: жар,
озноб, головная боль, недомогание и мышечная боль
(миалгия), диарея и состояние спутанности сознания.
spbu.ru
13. ЛЕГИОНЕЛЛЫ Legionella pneumophila (Л)
Род Legionella- 30 видовГр(-) бактерии
Диаметр 0,4 мкм, длина - 3 мкм, жгутики, спор и капсул нет.
АГ-структура: 47 серогрупп.
Токсины: эндотоксин, экзоферменты (пептидаза, гемолизины)
АМП- эритромицин, рифампицин, дез.средства.
Клетки легионеллы
Legionella pneumophila
(ТЭМ, ПО)
spbu.ru
14. 3 вопрос ХАРАКТЕРИСТИКА сем. Vibrionaceae
• Вибрионы (ТЭМ, метод негативного окрашивания)spbu.ru
15. ВЗАИМООТНОШЕНИЕ ВИБРИОНОВ С ЖИВОТНЫМИ И РАСТЕНИЯМИ
• Комменсалы морских и пресноводныхорганизмов: рыб, водорослей.
spbu.ru
16. СИМБИОЗ ВИБРИОНОВ С ВОДОРОСЛЯМИ
spbu.ru17. КОММЕНСАЛЫ МОРСКИХ И ПРЕСНОВОДНЫХ ОРГАНИЗМОВ: КРЕВЕТОК И РАЧКОВ
spbu.ru18. ВЗАИМООТНОШЕНИЯ ВИБРИОНОВ С ЧЕЛОВЕКОМ
• Вибрионы - паразиты животных и человекаspbu.ru
19. ЭВОЛЮЦИЯ сем. Vibrionaceae
• Древнейшие МО на Земле.• Из вибрионов-сапрофитов произошли патогенные
вибрионы.
• Трудности идентификации патогенных вибрионов
связаны с обнаружением непатогенных двойников.
spbu.ru
20. Зинаида Виссарионовна Ермольева (1898–1974)
1922 г. - провела на себе опасный для жизни опыт ссамозаражением холерным вибрионом.
1944 г.- создала отечественный пенициллинкрустозин
- первые отечественные образцы:
стрептомицина,
тетрациклина, левомицетина
и экмолина – первого антибиотика
животного происхождения
(из молок осетровых рыб).
spbu.ru
21. ЭВОЛЮЦИЯ сем. Vibrionaceae
ЭВОЛЮЦИЯсем. Vibrionaceae1. род Enhydrobacter (E. aerosaccus)свободноживущие.
2. р. Photobacterium – светящиеся (в
светящихся органах рыб)
непатогенные.
3. р. Aeromonas - патогенные для
животных, у человека (нехолерная
диарея).
4. р. Plesiomonas (P. shigelloides, ранее
известная как Aeromonas shigelloides –
дизентериеподобное заболевание,
энтериты, менингит у человека.
5. р. Vibrio – типовой род.
spbu.ru
22. СОВРЕМЕННАЯ ТАКСОНОМИЯ сем. Vibrionaceae (с 2020 г.)
AliivibrioAllomonas
Catenococcus
Corallibacterium
Echinimonas
Enterovibrio
Grimontia
Paraphotobacterium
р. Photobacterium
Photococcus
Salinivibrio
Thaumasiovibrio
р. Vibrio – типовой род.
spbu.ru
23. МОРФОЛОГИЧЕСКИЕ СВОЙСТВА ПРЕДСТАВИТЕЛЕЙ сем. Vibrionaceae
• Вибрионы - Гр- изогнутые и прямые палочки.• Диаметр – 0,5 мкм.
• Длина 2-4 мкм.
• У большинства жгутики.
• Спор и цист не образуют.
• Обнаружены покоящиеся формы.
spbu.ru
24. ПОКОЯЩИЕСЯ ФОРМЫ (ОКРУГЛЫЕ) V.cholerae (ТЭМ, метод ПО)
spbu.ru25. КУЛЬТУРАЛЬНЫЕ СВОЙСТВА ПРЕДСТАВИТЕЛЕЙ сем. Vibrionaceae
• Факультативные анаэробы• О/F тест +/+
(на среде Хью-Лейфсона окисляют и ферментируют
Д-глюкозу).
• без газа
• почти все вибрионы
оксидаза+
spbu.ru
26. 4 вопрос Род Vibrio Клетки вибрионов на поверхности ворсинок ЖКТ
spbu.ru27. ТАКСОНОМИЯ р.Vibrio
1.2.
3.
4.
5.
6.
7.
8.
V. cholerae – типовой вид
V. alginolyticus
V. fluvialis
V. metschnikovii
V. mimicus
V. parahaemolyticus
V. fisheri
V. vulnificus
(красные- совр. Таксономия с 2020 г.)
spbu.ru
28. ИТАЛЬЯНСКИЙ ВРАЧ Ф. Пачини Filippo Pacini (1812-1883)
1854 г. – Ф. Пачини в клиническомматериале пациента с диареей
обнаружил
палочку - Vibrio comma
spbu.ru
29. Роберт Кох (Германия)
• В начале V пандемии• 1883 г. выделил чистую культуру и доказал
этиологическую значимость V.cholerae
spbu.ru
30. Владимир Хавкин (1860-1930) (Россия)
• Создатель вакцин против холеры и чумы18 лет провел в Индии.
В 1897 г. - англ. королева Виктория вручила орден
Кавалера Индийской империи.
В 1909 г. - премия Парижской академии наук за вклад в
развитие медицинской науки.
В Бомбее В. Хавкину
установлен памятник, его
именем в Индии назван
Бактериологический институт.
.
spbu.ru
31. Врачи Ф.Готшлих и Е.Готшлих
• 1906 г. работали на Карантинной станции Эль-Тор.• Обнаружили новую разновидность вибрионов. Отличие:
вибрионы Готшлиха (эльтор) вызывали гемолиз
эритроцитов барана и козы.
spbu.ru
32. С 1961 г. VII пандемия - вибрион эльтор (Готшлиха)
С 1961 г. VII пандемия вибрион эльтор (Готшлиха)spbu.ru
33. 5 вопрос Биотипы вида V.cholerae
1. V.cholerae biotype cholerae –классический, азиатский
2. V.cholerae biotype eltor – эльтор
3. V.cholerae biotype proteus
(включает все не О1-НАГи)
4. V.cholerae biotype albensis
(флюоресцирующие)
spbu.ru
34. Морфология клеток V.cholerae (компьютерная графика)
spbu.ru35. Клетки V.сholerae, окраска по Граму
spbu.ru36. Клетки V.cholerae (CЭМ)
spbu.ru37. Культуральные свойства V.cholerae
• Опт. Тº - 37ºС• Хорошо переносят низкие Тº
• Сохраняют жизнеспособность во льду, холодной
воде - 1,5 мес.
• В речной воде, почве до 3 мес.
• Чувствительны ко всем дезинфектантам.
• Более устойчивы в окружающей среде –
вибрионы биотипа эльтор.
spbu.ru
38. РОСТ В ЖИДКОЙ ПИТАТЕЛЬНОЙ СРЕДЕ (ЖПС)
• Быстрый рост в щелочной пептонной среде,на поверхности - легкое помутнение, затем нежная
пленка.
spbu.ru
39.
Морфологияколоний
V.cholerae
spbu.ru
40. Биохимические свойства V.cholerae
• Классификация по Хейбергу (МАС)основана на отличии ферментации углеводов.
По МАС вибрионы делят 6 групп:
• 1 группа:
• 1. М манноза +
• 2. А арабиноза –
• 3. С сахароза +
• V.cholerae – 1-ая гр. по МАС
• (ферментирует арабинозу на 2-е сутки)
spbu.ru
41. ФЕРМЕНТАТИВНАЯ АКТИВНОСТЬ V.cholerae
Мощная протеолитическая активность• Образуют протеазы: разжижают желатин,
гидролизуют казеин и фибрин.
• Восстанавливают нитраты в нитриты.
• Образуют индол из триптофана.
• Экзоферменты:
• Лецитиназа
• Липаза
• РНК-аза
• Муциназа
• Нейраминидаза
• Гиалуронидаза
spbu.ru
42. 6 вопрос АГ- свойства вибрионов
• О-, Н- и К - АГ-комплексы• Н–АГ – видоспецифический для каждого вида.
• Все холерные и холероподобные вибрионы по
структуре О-АГ разделены на более, чем 100
серогрупп.
• Самые патогенные серогруппы О1 и О139.
• V.cholerae О139 – «Бенгал».
• Патогенные вибрионы
V.cholerae biotype cholerae и
V.cholerae biotype eltor принадлежат к О1
серогруппе, т.е. содержат О-АГ комплекс под №1.
spbu.ru
43. О1 АГ- комплекс V.cholerae состоит из 3-х компонентов: А,В,С
АВ – серовар Ogawa – самый агрессивный,с него начинаются вспышки холеры.
АС – серовар Inaba
АВС – серовар Hikojima
А-группоспецифический АГ -общий для
трех сероваров (серогрупп).
В,С –типоспецифические АГ
spbu.ru
44. Вибрионы НЕО1(НАГи)
Все вибрионы V.cholerae по морфологическим,культуральным и биохимическим свойствам идентичны.
V.cholerae биотип классический и
V.cholerae биотип эльтор - агглютинируются
сывороткой О1.
Среди V.cholerae есть биотипы, не агглютинирующиеся
сывороткой О1 - значит они лишены О1-АГ комплекса:
3 биотип НЕО1 – биотип proteus
4 биотип НЕО1 –биотип albensis (флюоресцирующие)
spbu.ru
45. 7 вопрос ГЛАВНЫЙ ФАКТОР ПАТОГЕННОСТИ
• Экзотоксин-холероген (ХГ)За синтез ХГ отвечает ген vct:
Токсигенные вибрионы vct+
Нетоксигенные вибрионы vctХГ - термолабильный белок
• Мол.масса- 84 кДа: А(А1иА2)+В
spbu.ru
46. Строение ХГ
• А1 – биологическая активность.• А2 – связь А1 и В.
• В – связь с мембраной за счет рецептора
эпителиоцита –ганглеозидом Gm1.
9-10
• Инфицирующая доза клеток вибриона- 10 .
• После присоединения ХГ усиливается активность
аденилатциклазы, образуется цАМФ,
• выход ионов Na+ и Cl-.
• Возникает альгидное состояние – у 17% гибель от
безвоживания и обессоливания.
spbu.ru
47. Холерный альгидный больной
spbu.ru48. «ХОЛЕРНЫЙ БАРАК»
spbu.ru49. СХЕМА ВОЗДЕЙСТВИЯ ХГ
spbu.ru50. ДЕЙСТВИЕ ХОЛЕРНОГО ТОКСИНА НА ЭПИТЕЛИОЦИТЫ (ТЭМ)
Рис. 1. Ультратонкийсрез эпителия тощей
кишки крысы при
инкубации с
холерным токсином
Ув. х5000;
Рис. 2. Ультратонкий срез
эпителия тощей кишки крысы.
Контроль.
Увеличение х5000
spbu.ru
51. ВОЗДЕЙСТВИЕ ХГ НА ЭПИТЕЛИОЦИТЫ – РАСШИРЕНИЕ МЕЖКЛЕТОЧНОГО ПРОСТРАНСТВА (ICS) (Markov A.G.,Falchuk E.L.,Kruglova N.M.,
Rybalchenko O.V., Fromm M., Amasheh S. Comparative analysis of theophylline and choleratoxin in rat colon reveals an induction of sealing tight junction proteins. Pflugers Archiv European Journal of Physiology, 2014. 466(11):
2059-65.)
spbu.ru
52. ФАКТОРЫ ПАТОГЕННОСТИ
• 1.Подвижность (жгутик (англ. holdfast) содержитадгезины)
• 2. Хемотаксис
• 3. Факторы адгезии и колонизации
• 4. Ферменты: муциназа, протеазы, нейраминидаза,
лецитиназа
• 5. Эндотоксин
6. Бактериоцины- подавление других МО.
7. Токсигенные вибрионы vct+
образуют экзотоксин-холероген.
spbu.ru
53. ПАТОГЕНЕЗ ХОЛЕРЫ
Клетки V.cholerae попадают в ЖКТ с водой и пищей.В тонкой кишке колонизируют слизистую оболочку,
размножаются и частично погибают, образуя эндотоксин.
Токсигенные вибрионы vct+ образуют экзотоксин-холероген .
ХГ прикрепляется к рецепторам – ганглиозидам эпителия- Gm1
и субъединица В проникает в клетку.
ХГ активизирует фермент аденилатциклазу, вызывая
гиперсекрецию клеток – водный эксикоз - потеря 4% массы тела
в пересчёте на воду. При недостатке 25% воды - кома и гибель.
Развивается изотоническая диарея, потеря жидкости в объемах,
не встречающихся при ОКИ другой этиологии.
Дегидратация ведет к нарушению гомеостаза, к гиповолемии, к
гипоксии, вызывая тромбогеморрагический синдром и острую
почечную недостаточность.
spbu.ru
54. ИММУНИТЕТ ПРИ ХОЛЕРЕ
• Неустойчивый.• Непрочный.
• Заболеть можно снова через 3-5 мес.
• Болеть можно повторно.
spbu.ru
55. 8 вопрос ЛАБОРАТОРНАЯ ДИАГНОСТИКА
• Серологические реакции не подходят(ретродиагностика)-потеря больного.
• Основные методы микробиологические:
микроскопия, биохимические тесты.
• O/F-тест +/+, но без газа, оксидаза+, окисление
трех сахаров по Хейбергу: МАС: (+ - +)
• Важный тест – фаготипирование!
spbu.ru
56. 9 вопрос ХОЛЕРНЫЕ ФАГИ Холерные фаги впервые выделены индийским врачом Шантану Мукерджи
spbu.ru57. 3 ГРУППЫ ФАГОВ ПО МУКЕРДЖИ
• 1. Монофаг холерный.• 2. Фаги Э-ТОР2 (4-6 час).
• 3. Набор поливалентных фагов.
• НО!
• Патогенная серогруппа О139 (Бенгал)– устойчива ко всем
фагам.
spbu.ru
58. НОСИТЕЛЬСТВО ВИБРИОНОВ
• Классический биотип – нет носительства.• Эльтор – есть носительство.
• Но все постоянно меняется!!!
spbu.ru
59. ЧУВСТВИТЕЛЬНОСТЬ К АМП
• Тетрациклин• От водного эксикоза соляные растворы:
• На 1 л Н2О:
• 3,5 г NaCO3+ 3,5 г KCl
• Глюкоза – 20 г
•Плазмозамещающие жидкости!!!
spbu.ru
60. ЭКСПРЕСС-ДИАГНОСТИКА ХОЛЕРЫ
spbu.ru61. 10 вопрос Характеристика патогенных вибрионов
Вибрионы, вызывающие кишечные заболевания:V.fluvialis - диарея
V.hollisae – диарея + бактериальная септицемия
V.mimicus - диарея + гнойные раны (после царапин в
воде) + отиты
V.parahaemolyticus – гастроэнтериты + бактериемия,
экстраинтестинальные инфекции глаз, ушей, раны
любой локализации.
spbu.ru
62. ВИБРИОНЫ, ВЫЗЫВАЮЩИЕ ЗАБОЛЕВАНИЯ ВНЕКИШЕЧНОЙ ЛОКАЛИЗАЦИИ (ВИБРИОЗЫ)
• V. vulnificus – самый агрессивный, обладаетмощными факторами патогенности –
септицемия, высокий % летальных исходов.
• V.metschnikovii – холецистит, бактериемия
• V.parahaemolyticus – парагемолитический
вибрион.
spbu.ru
63. V. parahaemolyticus
spbu.ru64. V.parahaemolyticus – парагемолитический вибрион
• Галофильный вибрион.• Выделен в Японии в 1950 г. - причина острого
гастроэнтерита (отравления зараженными
сырыми морепродуктами).
• Вызывает водную диарею, как при холере, но
иногда кровяную, как при дизентерии.
• Заболевание проходят в среднетяжелой форме,
часто само прекращается.
spbu.ru
65. Культуральные свойства V.parahaemolyticus
• Выделяют из испражнений на кровяном агаре безгемолиза.
• Требуется тщательная дифференциация от холерного
вибриона.
• Главный признак, по которому можно
дифференцировать - галофильность:
• без NaCl не растет вообще,
• при 3% NaCl рост начинается,
• при 7-8% NaCl – хороший рост,
• другие представители р.Vibrio – не растут.
Питательная среда CHROMagar Vibrio помогает легко
дифференцировать V. parahaemolyticus, V. vulnificus и
V. cholerae от других вибрионов.
spbu.ru
66. БИОХИМИЧЕСКИЕ СВОЙСТВА V.parahaemolyticus
• 7-я группа по Хейбергу:• М - манноза +
• А - арабиноза +
• С - сахароза –
• Смит и Гудвин
добавили 2 группы
к 6-ти по Хейбергу.
• Итого МАС - 8 групп.
spbu.ru
67. V. рarahaemolyticus НА ТИОСУЛЬФАТ-ЦИТРАТНОМ АГАРЕ
spbu.ru68. V. parahaemolyticus НА ХРОМ-АГАРЕ
spbu.ru69. V.parahaemolyticus
• Профилактика:• Термическая обработка морских продуктов.
• Чувствительность к АМП: Тетрациклин – кишечные формы.
• Поддерживающий режим.
spbu.ru

medicine
medicine








